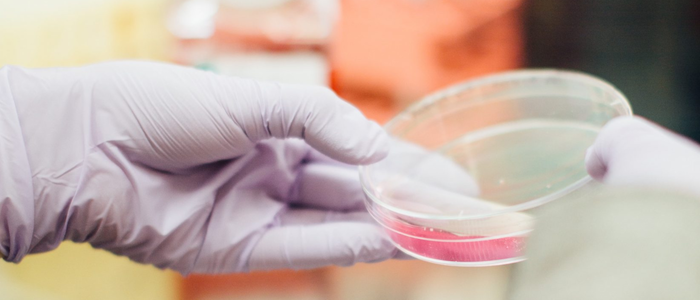
Convenzione Brugnoni Group con sedi con a Perugia, Foligno e Città di Castello

Convenzioni per i cittadini e pensionati
Scopri tutte i vantaggi per gli Associati
Associarsi a CNA significa anche ottenere tanti vantaggi esclusivi quando vuoi acquistare un mezzo, prenotare una vacanza, comprare un nuovo telefono o un computer, tutelare la tua salute e tantissimo altro ancora!
Entra a far parte della community CNA e scopri l’intera gamma di opportunità che offriamo ai nostri associati!

Convenzioni nazionali
CNA, attraverso ServiziPIÙ, offre agevolazioni per te e la tua famiglia, su numerosi prodotti e servizi con un network di importanti partner italiani e internazionali. Per te oltre 100 opportunità e offerte!
Per te oltre 100 opportunità e offerte!


Mobilità
Acquisto auto e moto a noleggio.

Utilità
Assistenza fiscale, fit prime; Prodotti per la casa lampada.it; Prodotti per la persona (Adidas, Chicco, Levi's,...)

Editoria
Class editori, Grandi clienti Mondadori, Rassegna stampa.

Tecnologia
Elettronica e informatica: Apple, Electrolux, Garmin, Huawei, Lenovo, Samsung.

Turismo
Bluserena Eden Viaggi Hotels...
Convenzione CNA UnipolSai
-

Polizza assicurazioni scippo e rapina
-

Polizza assicurazioni infortuni e grandi interventi chirurgici
Convenzioni Territoriali
-

Convenzione Fisioterapia Farnetani
Per gli associati CNA SCONTO sui servizi indicati
-

Convenzione Bioanalisi - Madonna del Buon Consiglio
Per gli associati CNA SCONTO sui servizi indicati
-

Convenzione Centro Medico Cairoli
Per gli associati CNA SCONTO sui servizi indicati
-

Convenzione C.M.S. Centro Medico Spoleto
Per gli associati CNA SCONTO sui servizi indicati
-

Convenzione Parafarmacia Pian di Porto
Per gli associati CNA SCONTO sui servizi indicati
-

Convenzione Planet Sport
Per gli associati CNA SCONTO sui servizi indicati
-

Convenzione Medplus
Per gli associati CNA SCONTO sulle prestazioni indicate
-

Convenzione CRABioN Laboratorio Analisi
Per gli associati CNA SCONTO sulle prestazioni indicate
-

Convenzione Studio Alessio Cencini Fisioterapia e Osteopata
Per gli associati CNA SCONTO sulle prestazioni indicate
-

Convenzione Centro Fisioterapico Clitunno
Per gli associati CNA SCONTO sulle prestazioni indicate
-

Convenzione Bewater Martial Arts
Per gli associati CNA SCONTO sulle attività indicate
-

Convenzione Medico dentista Eleonora Marietti
Per gli associati CNA SCONTO sulle prestazioni indicate
-

Convenzione Hippocrates Centro Medico
Per gli associati CNA SCONTO sulle prestazioni indicate
-

Convenzione Farmacia Menconi
Per gli associati CNA SCONTO sulle prestazioni indicate
-

Convenzione Centro Medico Umbro
Per gli associati CNA SCONTO sulle prestazioni indicate
-

Convenzione Centro Salute Selva
Per gli associati CNA SCONTO sulle prestazioni indicate
-

Convenzione Fisiogama
Per gli associati CNA SCONTO sulle prestazioni indicate
-

Convenzione Medicina Umbria di Fisiogama
Per gli associati CNA SCONTO sulle prestazioni indicate
-

Convenzione Centro Chiroterapico Umbro
Per gli associati CNA SCONTO sulle prestazioni indicate
-

Convenzione Centro Medico Dott. Giulio Loreti
Per gli associati CNA SCONTO sulle prestazioni indicate
-

Convenzione LAB 2000
Per gli associati CNA SCONTO sulle prestazioni indicate
-

Convenzione Ambulatorio di fisioterapia DAVID SERVICE
Per gli associati CNA SCONTO sulle prestazioni indicate
-

Convenzione CTF Medical
Per gli associati CNA SCONTO sulle prestazioni indicate
-

Convenzione Ainoa Centro Medico Polispecialistico
Per gli associati CNA SCONTO sulle prestazioni indicate
-

Convenzione Studio Dott. Massimo Pizziconi
Per gli associati CNA SCONTO sulle prestazioni indicate
-

Convenzione Gruppo Cidat
Per gli associati CNA SCONTO sulle prestazioni indicate
-

Convenzione Umbria Udito
Per gli associati CNA SCONTO sulle prestazioni indicate
-
Convenzione Brugnoni Group Sanità
Per gli associati CNA SCONTO sulle prestazioni indicate
-

Convenzione Centro Medico Spazio Salute srl
Per gli associati CNA SCONTO sulle prestazioni indicate
